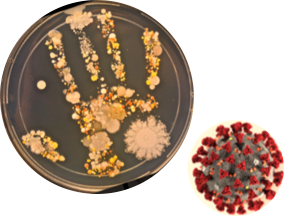

全球大流行傳染病-新冠肺炎(COVID-19),有一件事情不斷的被宣導,那就是「勤洗手」!因為洗手這個動作被證實能夠有效去除手上所沾染病菌,可避免病菌隨著手的觸碰被感染到,或是成為散播病菌的幫手。以下資訊將教民眾正確的洗手,並搭配實驗證實確實洗手的重要性:
至少洗超過 20 秒,婦產科名醫鄭丞傑教授在臉書上分享一則影片,講明了為什麼用肥皂洗手至少 20 秒才有效,實驗中使用了特殊乳液『在紫光燈照射下會呈現螢光』作為細菌。第一次先使用清水洗手,然後又在紫光燈照射下,會發現雙手仍有螢光色,又測試了用肥皂洗了 5 秒跟 10 秒手的差別,還是發現雙手的螢光顏料仍未被洗掉,最後一次是試驗用肥皂洗手 20 秒,才將手上的螢光顏料給洗掉!( 如下圖 )

新光醫院急診醫學科主任張志華醫師說明洗手步驟「內、外、夾、弓、大、立、完」張志華醫師表示,不要小看洗手這個動作,裡頭可以藏有很大的學問,建議每個步驟過程需要搓洗 40~ 60 秒,才是有效的洗手喔!「內是搓手心,外是搓手背,夾是搓指縫,弓是搓指背,大是搓大拇指和虎口,立是搓指尖,完是沖乾淨並擦乾。」

洗手的方式有兩種,除了濕洗手 ( 使用肥皂或具去汙作用的洗手劑洗手 ) ,還有乾洗手 ( 使用酒精性乾洗手液洗手 ) 。但是這邊強調,濕洗手是最徹底的洗手方式,而乾、濕洗手二擇一即可,會選擇乾洗手是最不得已的方式,乾洗手是應急使用;且濕洗手全程時間約需40至60秒,乾洗手全程時間則約20至30秒。不只防疫期間確實洗手,平日養成良好的洗手習慣!並在「回家後」、「用餐前後」、「接觸小孩或長輩前」要洗手,隨時保持良好衛生習慣,就能降低感染風險。
美國科羅拉多大學曾做過一項研究,用偵查細菌 DNA 的方式,發現了每人手上的細菌種類大約有 150 種,此研究共有 51 名大學生參與,研究人員從他們的手上發現了近 5000 種不同的細菌,有些細菌易造成人體免疫力下降,如此驚人數據顯示防疫期間不斷宣導洗手的重要性。
另有研究也表示,平均每個人的雙手都攜帶 1000 萬個細菌,比電梯扶手、公園長椅還要髒!由以上數據來看,「洗手」是很重要的事,因為沒有人想帶著細菌移動,成為散播者,勿用清水帶過洗手。